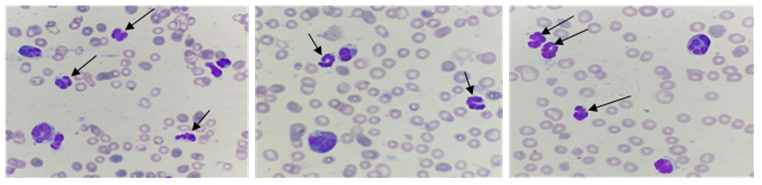

Anvari S, Kheyrandish S, Sotudeh F, Mirpour Hasankiadeh H, Khanaki K, Shahabi Satlsar E. Chronic basophilic leukemia; A rare myeloproliferative disorder and the role of flow cytometry for its diagnosis. mljgoums 2025; 19 (2) :38-40
URL:
http://mlj.goums.ac.ir/article-1-1641-en.html
1- Regenerative Medicine, Organ Procurement and Transplantation Multi-diciplinary Center, Razi Hospital, School of Medicine, Guilan University of Medical Sciences, Rasht, Iran
2- Hematology and Blood Banking Department, Shahid Beheshti University of Medical Sciences, Tehran, Iran
3- Langeroud School of Paramedical Sciences, Guilan University of Medical Sciences, Rasht, Iran
4- Department of Internal Medicine, School of Medicine, Guilan University of Medical Sciences, Rasht, Iran
5- Langeroud School of Paramedical Sciences, Guilan University of Medical Sciences, Rasht, Iran , esmaeilshahabi@yahoo.com
Full-Text [PDF 747 kb]
(711 Downloads)
|
Abstract (HTML) (2433 Views)
Full-Text: (257 Views)
Introduction
Chronic basophilic leukemia (CBL) is not recognized as a new entity or classified as a unique myeloproliferative disorder (MPD) in the new World Health Organization (WHO) classification (1). According to the literature review, a few cases have been reported as primary CBL and this disorder has remained an extremely rare condition (2). An important challenge in diagnosing chronic basophilic leukemia is misdiagnosis of CBL as chronic eosinophilic leukemia (CEL) due to the remarkable increase in eosinophils, and abnormal basophils morphologies like hypersegmentation and hypogranulation (3). In an extensive screening to search for new groups of rare MPDs, Paradanani et al. reviewed electronic databases from 1975 to 2003. They observed four cases with a high percentage of basophils in differential counting and two cases with basophilic leukemia manifestations (4). The bone marrow (BM) examinations of the two latter cases revealed trilineage hyperplasia with active presence of basophils and eosinophils, along with the increased numbers of dysplastic megakaryocytes without clustering. A remarkable increase in basophil counts is a common manifestation of chronic myeloid leukemia (CML) (5). In the accelerated phase of CML, the morphology of basophils is usually typical with frequent presence of many basophilic granules in the cytoplasm without nuclear hypersegmentation; however, dysplastic features are also common manifestations (5). On the contrary, in reported cases as primary CBL, the peripheral blood smear (PBS) represented dysplastic basophils with hyperlobulated nuclei besides hypogranular cytoplasm (With fine granules). The hypersegmented basophils were also observed in the BM smear of these patients (6). According to the presented data, patients with CBL may be classified as having either myeloproliferative disease not otherwise specified (MPD-NOS) or chronic eosinophilic leukemia (CEL), due to the frequent misdiagnosis and underrecognition of CBL. Lack of specific signs in patients with primary CBL or secondary basophilia mimicking CBL makes it difficult to accurately diagnose.
Case presentation
A 47-year-old woman was admitted to the internal clinic at Razi Hospital in Rasht, (Guilan Province, Iran). At the time of presentation, the patient did not have any underlying disease or family history of leukemia. The clinical presentation was gastrointestinal symptoms and bloating with laboratory findings of leukocytosis (50,000/µL) and eosinophilia exceeding 50.0%. Therefore, she was referred to the hematology clinic. At the first step of evaluation, anti-fasciola medications were utilized. However, the complication did not improve and after one week, albendazole was prescribed. Due to the persistent clinical findings and leukocytosis, the patient was referred to the hematology clinic for the second time. Here, the patient presented splenomegaly, so for more extensive evaluations, BM aspiration and biopsy were performed. In addition, molecular assessment of Jak2, BCR-ABL, cMPL, CALR, PDGFRa, PDGFRb and FGFR1 was carried out to rule out MPDs; nevertheless, all of these tests were negative. After examining the BM specimen, chronic myelomonocytic leukemia (CMML) was the probable diagnosis. The patient was managed with hydroxyurea, prednisolone, cytosar, imatinib, and splenectomy. After a while, other complications like retina bleeding occurred; therefore, to prevent these conditions and avoid severe thrombocytopenia and anemia, the treatment was continued using imatinib with no further drugs. This led to palliation of clinical and laboratory (Leukocytosis) findings for three months. Once again, BM aspiration and biopsy were repeated. This time, MPD was suspected, so prednisolone, hydroxyurea, imatinib, and cyclosporine were prescribed; however, her clinical findings were still persistent. For further evaluations, aspiration and biopsy of the BM were performed for the third time and the specimen was referred to our laboratory. In this step, in addition to leukocytosis, she presented with anemia, thrombocytopenia, and fatigue. The PBS examination showed increased leukocytes with eosinophilia besides hypersegmented (With individual nuclear lobes) and hypogranular leukocytes. Few of these cells showed fine granulation (Figure 1). Blasts were less than 1.0% and the other types of leukocytes were rarely seen.
BM smear showed similar findings with dysplastic megakaryocytes. After precise observation of these findings, flow cytometry was performed on the BM sample using the following markers: HLA-DR, CD3, CD5, CD19, CD10, CD13, CD33, CD14, CD64, CD117, CD38, CD25, CD34, and CD45. Based on the dot plot in forward versus side scatter, medium-sized leukocytes with lower side scatter were observed (Figure 2) and this pattern was similar to AML-M4/M5 blastic flow cytometry pattern. These specific cells were positive for CD13, CD33, CD38, CD25, and CD45mod, and negative for other myeloid and lymphoid markers (Figure 2).
Figure 1. Bone marrow smears show an increase in eosinophils and the presence of many hypogranular and hypersegmented leukocytes (Arrows)

Figure 2. Flow cytometry dot plot reveals expression of CD13, CD33, CD25, CD38, CD45 mod. CD14 and CD64 were negative in the selected population
|
According to the morphological and immunophenotyping findings, approximately 42.0% basophil and 30.0% eosinophil were identified in the BM sample confirming the diagnosis of MPD-NOS (CBL). In order to improve clinical symptoms, mepolizumab was added to other mentioned drugs. After observing the skin masses, the possibility of chloroma was suggested and following the administration of interferon, the clinical symptoms subsided and the patient was considered as a candidate for BM transplantation.
Discussion and Conclusion
Basophils are distinct hematopoietic cells, and basophilia is seen in some myeloid neoplasms, including CML. Basophils are markedly increased in the accelerated phase of CML and may generate clinical findings in some patients (7). The CBL is a rare disorder, and precise evaluation of clinical manifestations and the use of new laboratory methods are necessary to avoid unnecessary treatment (4). In the present case, morphological findings were not suitable for differentiating CBL from CEL, and in addition to the increase of eosinophils, basophils did not have typical morphology. For these reasons, misdiagnosis would be so probable. Most of the basophils of this case were hypersegmented and their nuclei had individual lobes. Hypogranulation and the presence of a few fine granules were other special findings. These unusual morphologies besides eosinophilia would enhance suspicion of CBL detection. The morphological findings were not reliable enough; thus, flow cytometry evaluation was essential for a definitive diagnosis. Basophils have moderate CD45 expression and low side scatter pattern (8), and express CD123, CD9, CD22, CD13, CD33, CD36, CD38, CD25, and CD45mod (9), but eosinophils do not express CD25 or CD38 and are positive for CD45 (Bright expression), CD13, CD33, CD15, CD11b, and CD11c, which can all guide us toward a more specific and time-saving diagnosis of CBL.
The findings of the present case were partially similar to those of case 6 and the accelerated phase of the same patient reported by Chehreli et al. In that case, the increased basophils in the PB and BM,
basophils and eosinophils, dysplasia of eosinophilia, hypercellularity of BM, and dysplastic megakaryocytes were evident (10,11).
In the 6-month follow-up of this case, despite receiving the mentioned drugs, no improvement was seen. Based on these findings and also the findings of above-mentioned reviews and proposed diagnostic criteria (2), it is suggested that patients who have these presentations should be evaluated for the expression of CD13, CD33, CD38, CD25, CD45, forward scatter, and side scatter. The present findings contribute to the previously reported data and support the proposed criteria for the diagnosis of primary CBL.
Acknowledgement
Thanks to Hadi Hajizadeh Fallah, technical director of Jam Pathobiology Laboratory.
Funding sources
None.
Ethical statement
Informed consent was obtained from the patient and the patient was assured that her information would remain confidential.
Conflicts of interest
The authors declare they have no conflict of interest.
Author contributions
The authors equally contributed to this article.
Data availability statement
The data supporting the findings of this study can be obtained from the corresponding author upon request.
Research Article:
Case Report |
Subject:
Laboratory hematology Received: 2023/03/12 | Accepted: 2023/07/17 | Published: 2025/04/6 | ePublished: 2025/04/6
References
1. Khoury JD, Solary E, Alba O, Akkari Y, Alaggio R, Apperley JF, et al. The 5th edition of the World Health Organization Classification of Haematolymphoid Tumores: Myeloid and Histiocytic/Dendritic Neoplasm. Leukemia. 2022;36(7):1703-19. [
View at Publisher] [
DOI] [
PMID] [
Google Scholar]
2. Cehreli C. Diagnostic problems in chronic basophilic leukemia. Turk J Hematol. 2018;35(4):283-9. [
View at Publisher] [
DOI] [
PMID] [
Google Scholar]
3. Valent P, Sotlar K, Blatt K, Hartmann K, Reiter A, Sadovnik I, et al. Proposed diagnostic criteria and classification of basophilic leukemia and related disorders. Leukemia. 2017;31(4):788-97. [
View at Publisher] [
DOI] [
PMID] [
Google Scholar]
4. Pardanani AD, Morice WG, Hoyer JD, Tefferi A. Chronic Basophilic Leukemia: a distinct clinic-pathologic entity? Eur J Hematol. 2003;71(1):18-22. [
View at Publisher] [
DOI] [
PMID] [
Google Scholar]
5. Bain BJ, Heller M. Dysplastic basophils in the accelerated phase of chronic myelogenous leukemia. Am J Hematol. 2011;86(11):949. [
View at Publisher] [
DOI] [
PMID] [
Google Scholar]
6. Tang G, Woods LJ, Wang SA, Brettler D, Anderson M, Miron PM, et al. Chronic Basophilic Leukemia: a rare form of chronic myeloproliferative neoplasm. Hum Pathol. 2009;40(8):1194-9. [
View at Publisher] [
DOI] [
PMID] [
Google Scholar]
7. Valent P, Horny HP, Arock M. The underestimated role of basophils in Ph+ chronic myeloid leukemia. Eur J Clin Invest. 2018;48(10):e13000. [
View at Publisher] [
DOI] [
PMID] [
Google Scholar]
8. Stacchini A, Demurtas A, Godio L. Flow cytometric detection of of degranulated basophils in chronic myeloid leukemia in accelerated phase. Cytometry B Clin Cytom. 2011;80B(2):122-4. [
View at Publisher] [
DOI] [
PMID] [
Google Scholar]
9. Han X, Jorgensen JL, Brahmandam A, Schlette E, Huh YO, Shi Y, et al. Immunophenotypic study of basophils by multiparameter flow cytometry. Arch Pathol Lab Med. 2008;132(5):813-9. [
View at Publisher] [
DOI] [
PMID] [
Google Scholar]
10. Chehreli C, Ates H, Chehreli R, Sercan Z, Demirkan F. New paraneoplastic syndrome in chronic basophilic leukemia. Int J Hematol. 2013;97(4):498-504. [
View at Publisher] [
DOI] [
PMID] [
Google Scholar]
11. Cehreli C, Alacacioglu I, Piskin O, Ates A, Cehreli R, Calibasi G, et al. Mast cell leukemia associated with undefined morphology and chronic basophilic leukemia. BMC Hematol. 2014;14:17. [
View at Publisher] [
DOI] [
PMID] [
Google Scholar]